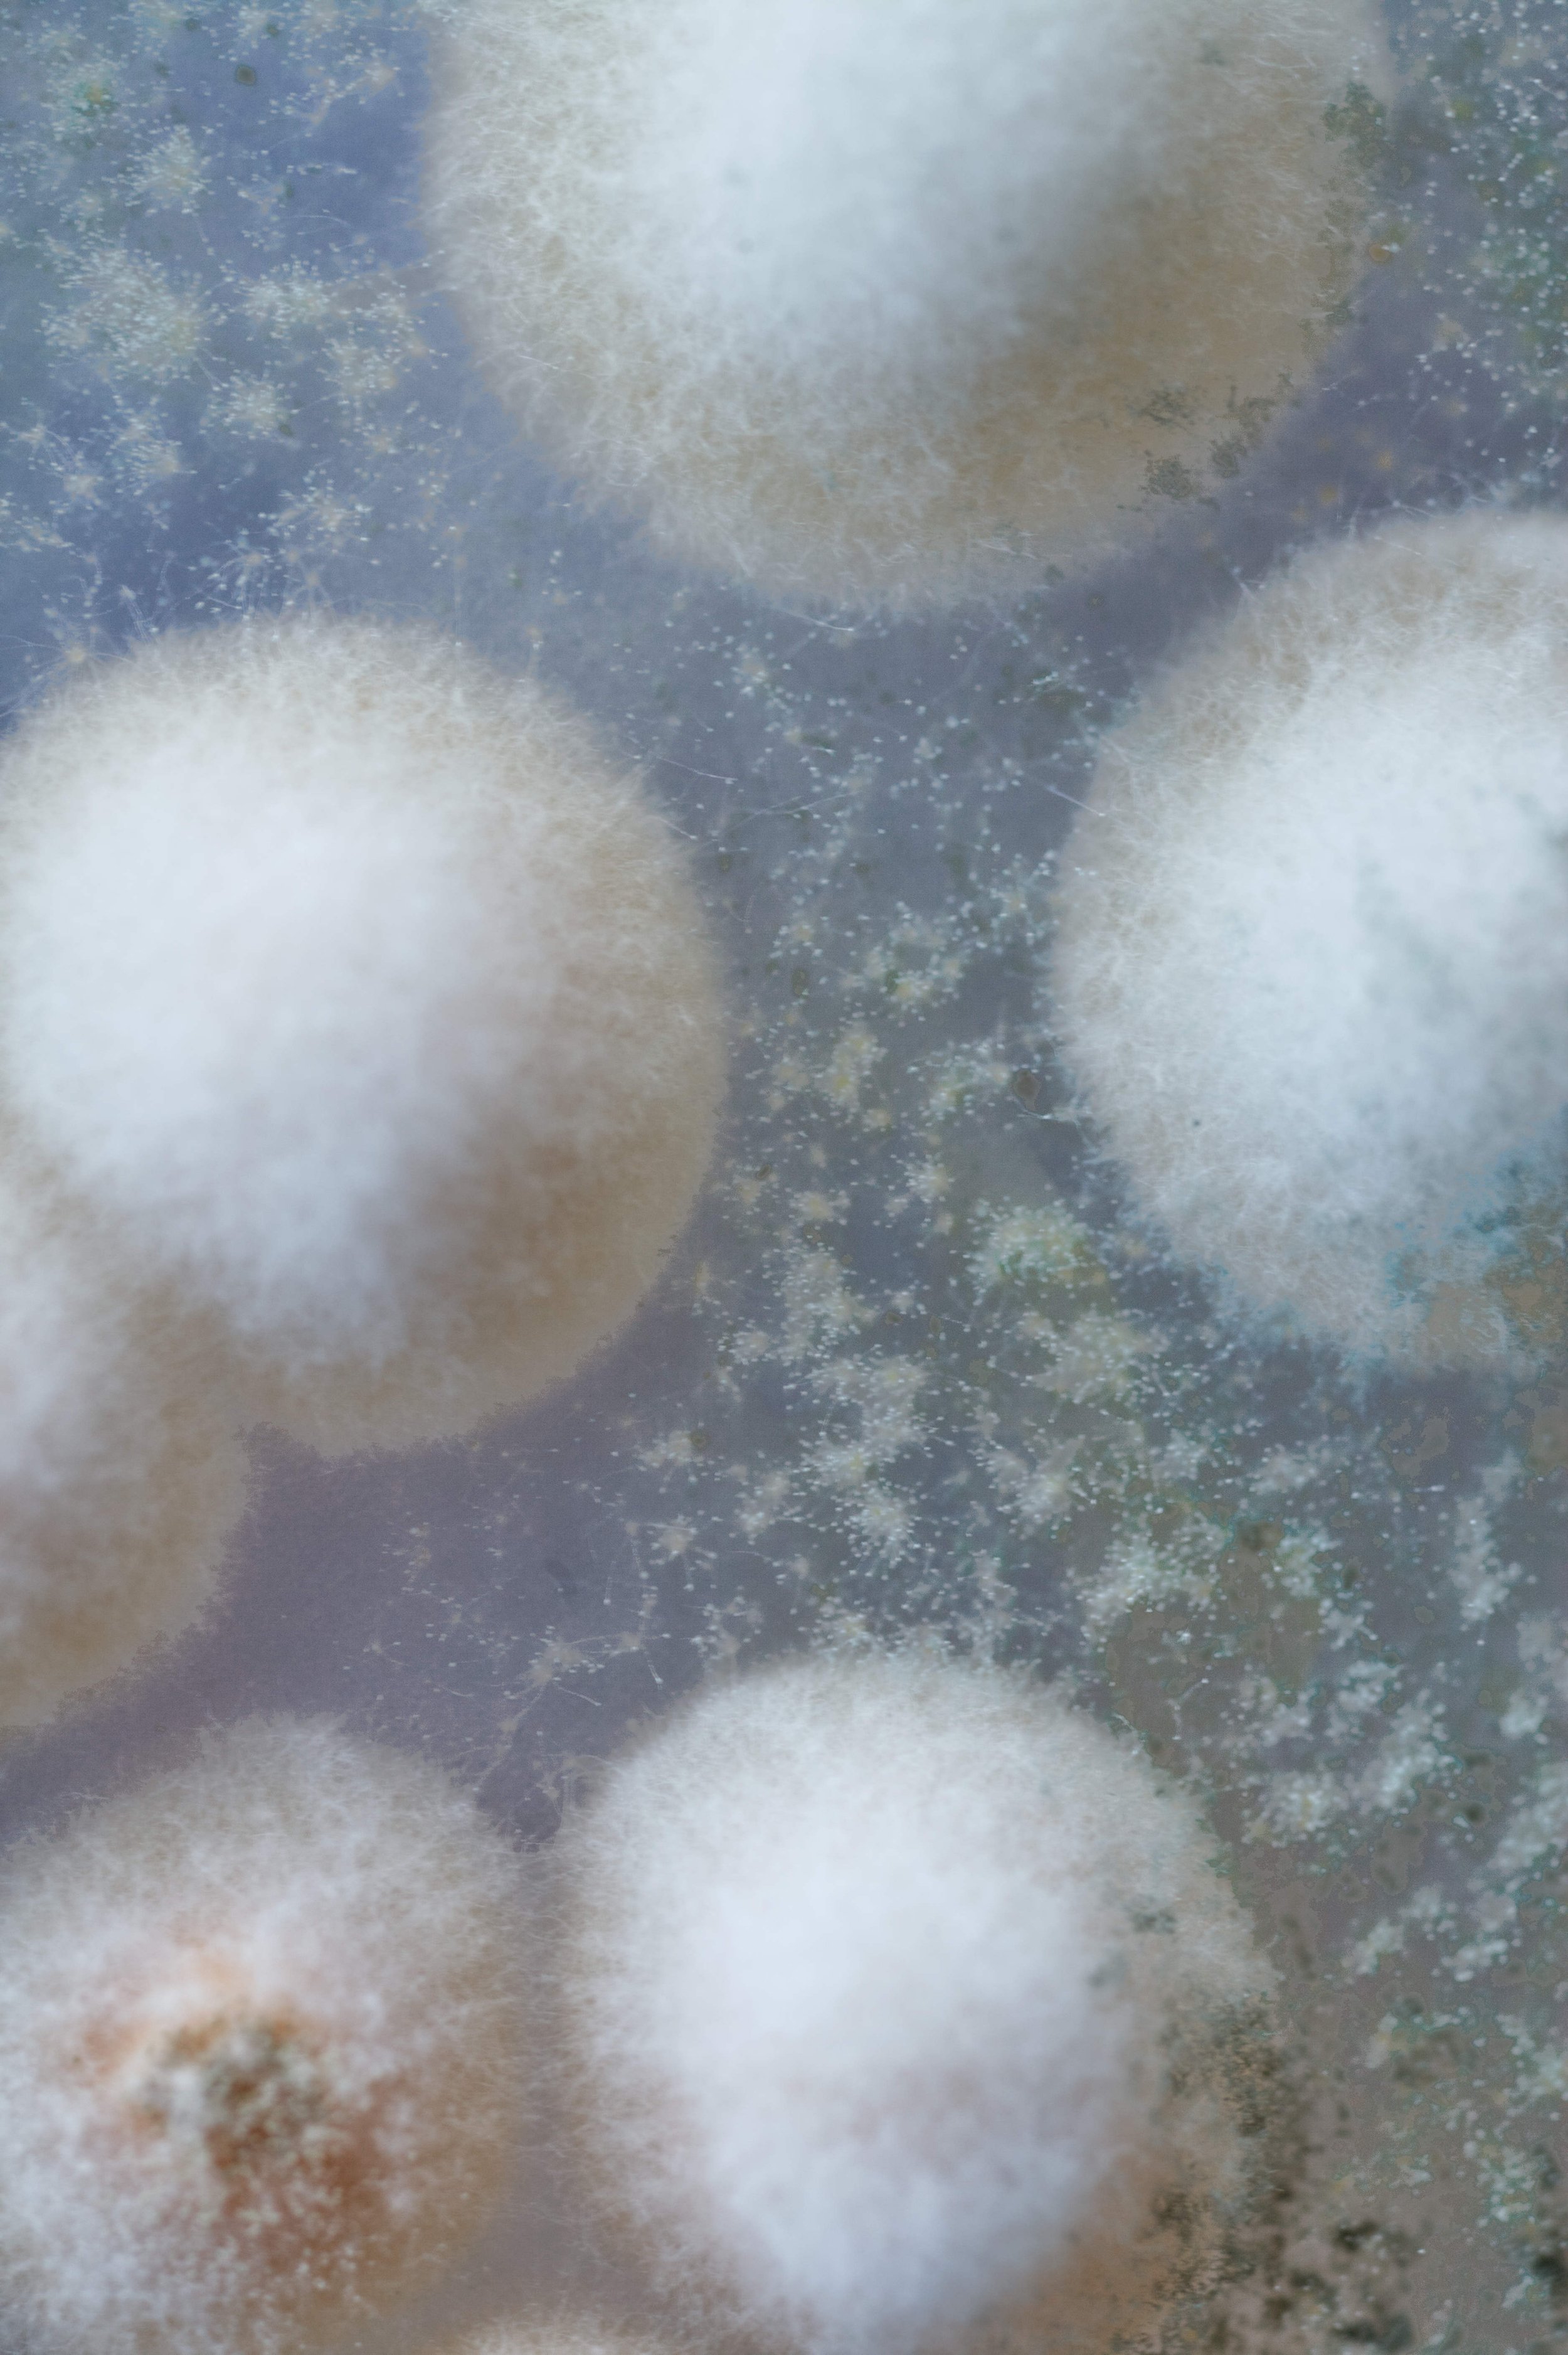
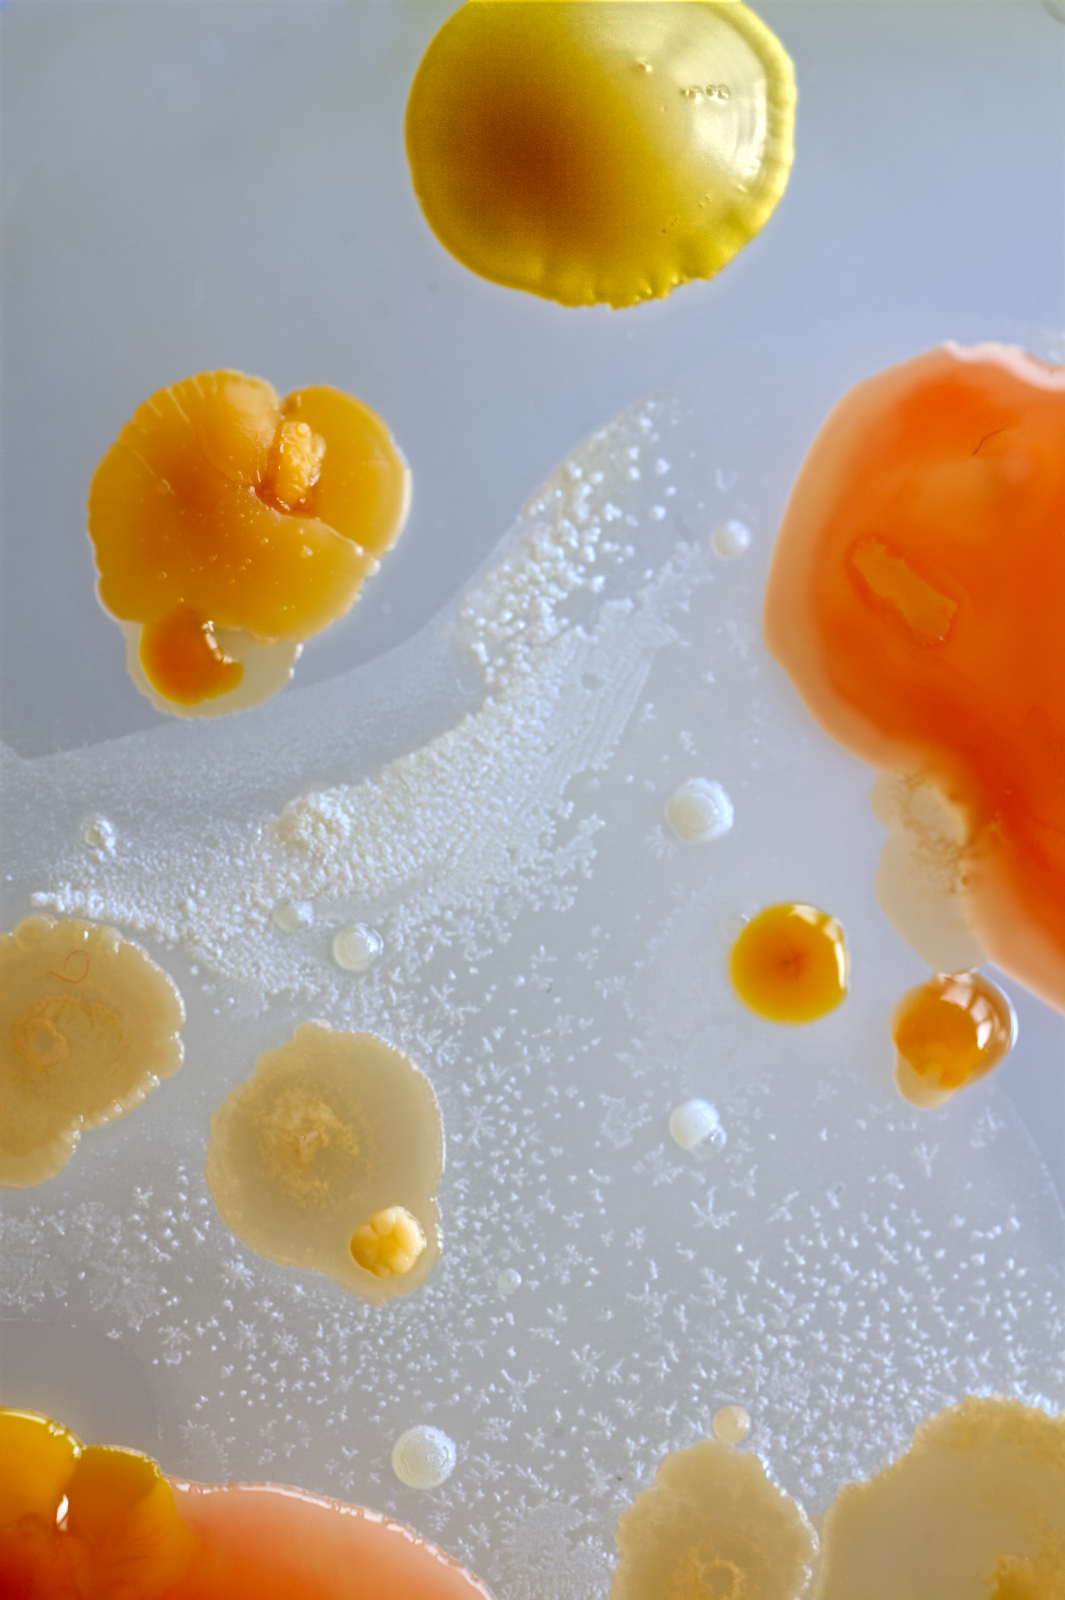

Gewone melk
"Ordinary Milk" is a photographic series of seven macro images capturing microbial cultures grown from the artist’s own breastmilk. By cultivating and documenting these living ecosystems, the work visualizes the microbiome as both biological and symbolic – a portrait of maternal connection, resistance, and care. Referencing mycelial networks, the series reflects on how health, like community, is rooted in exchange, diversity, and interdependence. The title challenges societal taboos and reframes human milk as the true “ordinary” milk. In doing so, the work questions systems that commodify care while rendering its most essential forms invisible and undervalued.
These cultures, emerging from mother’s milk in petri dishes, reveal a biological landscape of remarkable diversity. Each formation represents not merely an artistic medium, but a living testament to the complex microbiome that strengthens the mother-child bond.
The intricate patterns and varied pigmentations visible through macro photography speak to the biological specificity of each mother’s milk - a substance uniquely calibrated to support her child’s development and immune system.
This diversity mirrors how communities thrive not through uniformity, but through complementary differences and interconnection.
What manifests in these dishes transcends aesthetic appeal, becoming an inquiry into how health itself is relational. The microbiome passed from mother to infant establishes foundational communities of beneficial bacteria that influence lifelong health outcomes.
These living systems challenge our individualistic conceptions of wellbeing, suggesting that instead health emerges from relationship and exchange.
Therefore these cultures become portraits of connection - visual representations of how mothers prepare their children for the world, offering both nourishment and the foundations for community within and outside of their bodies.